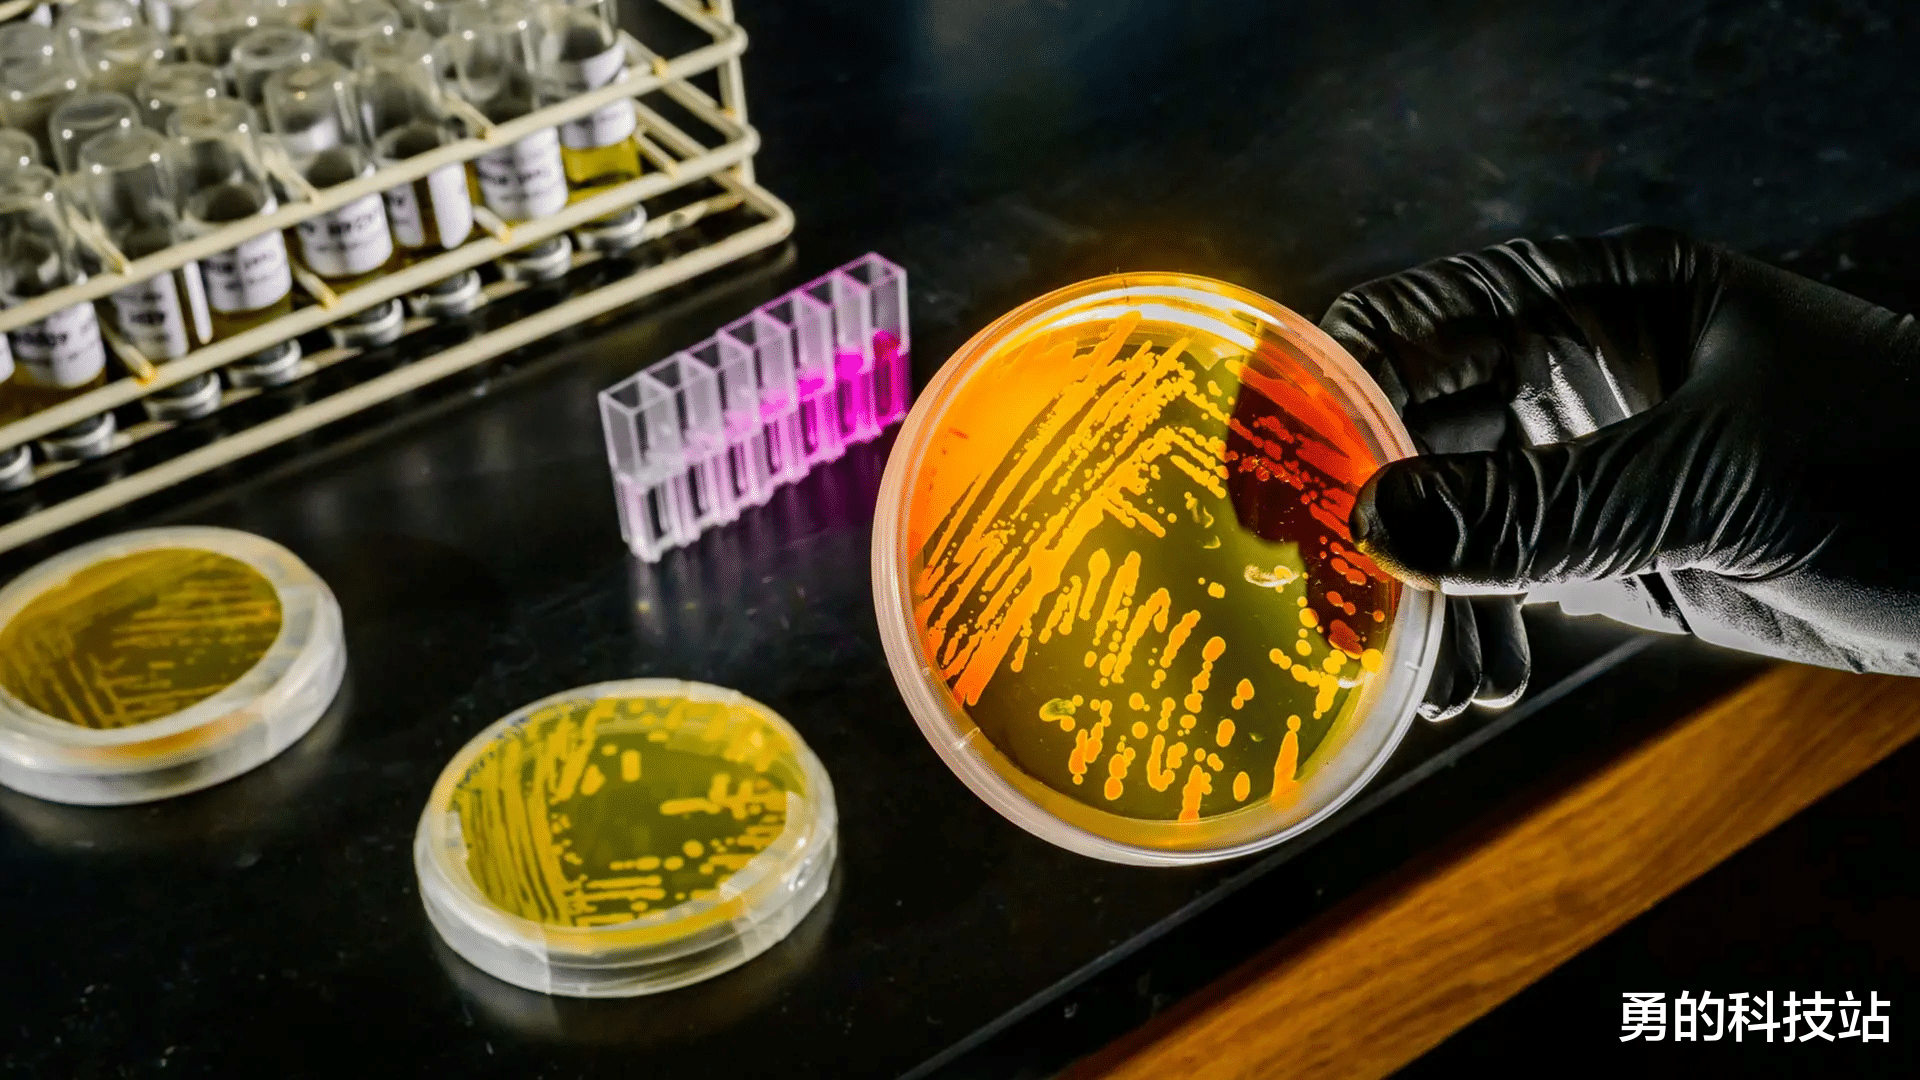

由伊利诺伊大学厄巴纳-香槟分校联合领导的一个研究团队预测,一种令人惊讶的适应性极强的海洋古菌物种将在气候变化中重塑地球海洋的生物多样性中发挥重要作用。图片来源:弗雷德·兹维基
海洋温度升高,海洋热浪与气候变化将热能传递至深海,威胁海洋脆弱的化学与生物系统。
然而,最新研究表明,关键海洋微生物 Nitrosopumilus maritimus 可能已在适应更温暖、更缺乏营养的环境。科学家认为,这种高度依赖铁并进行氨氧化的适应性微生物,随着气候持续变化,可能会显著影响海洋中养分的分布。
研究成果发表在《美国国家科学院院刊》(Proceedings of the National Academy of Sciences)。
支撑海洋养分循环的微生物Nitrosopumilus maritimus 与其近缘微生物约占海洋微生物浮游生物的 30%。许多科学家认为它们对海洋化学至关重要,因为它们驱动支持海洋生态系统的反应。
这些古菌氧化氨,氨氧化是海洋氮循环中的核心过程。通过将水中氮转化为不同化学形式,它们调节浮游生物的生长。作为海洋食物链的基础,这些微小生物的氨氧化活性最终帮助维持海洋生物多样性。
深海升温可能改变铁的利用伊利诺伊大学厄本那-香槟分校微生物学教授魏秦(Wei Qin)表示:
“海洋升温的影响可能扩展到 1,000 米甚至更深的水层。” “我们过去认为深层水主要受到表层升温的隔离,但现在已越来越清楚,深海升温会改变这些丰富古菌对铁的使用——铁是它们高度依赖的金属——从而可能影响深海微量金属的可获得性。”
实验显示微生物在更温暖的水中更高效地使用铁研究团队由秦教授与南加州大学全球变迁生物学教授大卫·哈钦斯(David Hutchins)领导,开展了严格控制、避免微量金属污染的实验。
他们将纯培养的 Nitrosopumilus maritimus 暴露于不同温度与不同铁浓度下。
实验结果表明:在铁受限条件下,温度升高时,微生物需要更少的铁且使用更高效。
这表明这些生物能够通过调节代谢来应对更高温度与铁供应减少的双重挑战。
模型预测未来海洋化学中其作用将更大“我们将这些发现与利物浦大学阿尔贝托·塔利阿布(Alessandro Tagliabue)的全球海洋生物地球化学模型相结合。” “结果表明,在全球升温的气候下,深海古菌群落可能维持甚至增强其在氮循环与初级生产支持方面的作用,尤其是在广阔铁受限区域。”
即将开展的海洋考察验证实验结果今年夏季,秦与哈钦斯将担任研究船 Sikuliaq 的共同首席科学家。
这次远征将从西雅图出发前往阿拉斯加湾,然后继续前往亚热带环流,途经夏威夷檀香山停留。
航行将带来 20 位额外研究人员,重点研究海洋中自然古菌种群。其目标是验证实验结果在实际海况下的适用性,并更好地理解温度变化与金属可获得性如何相互作用,塑造深海微生物活性。
秦教授亦隶属于 Carl R. Woese 基因组生物学研究所。
勇编撰自论文"Ocean warming enhances iron use efficiencies of marine ammonia-oxidizing archaea".Proceedings of the National Academy of Sciences.2026相关信息,文中配图若未特别标注出处,均来源于自绘或公开图库。